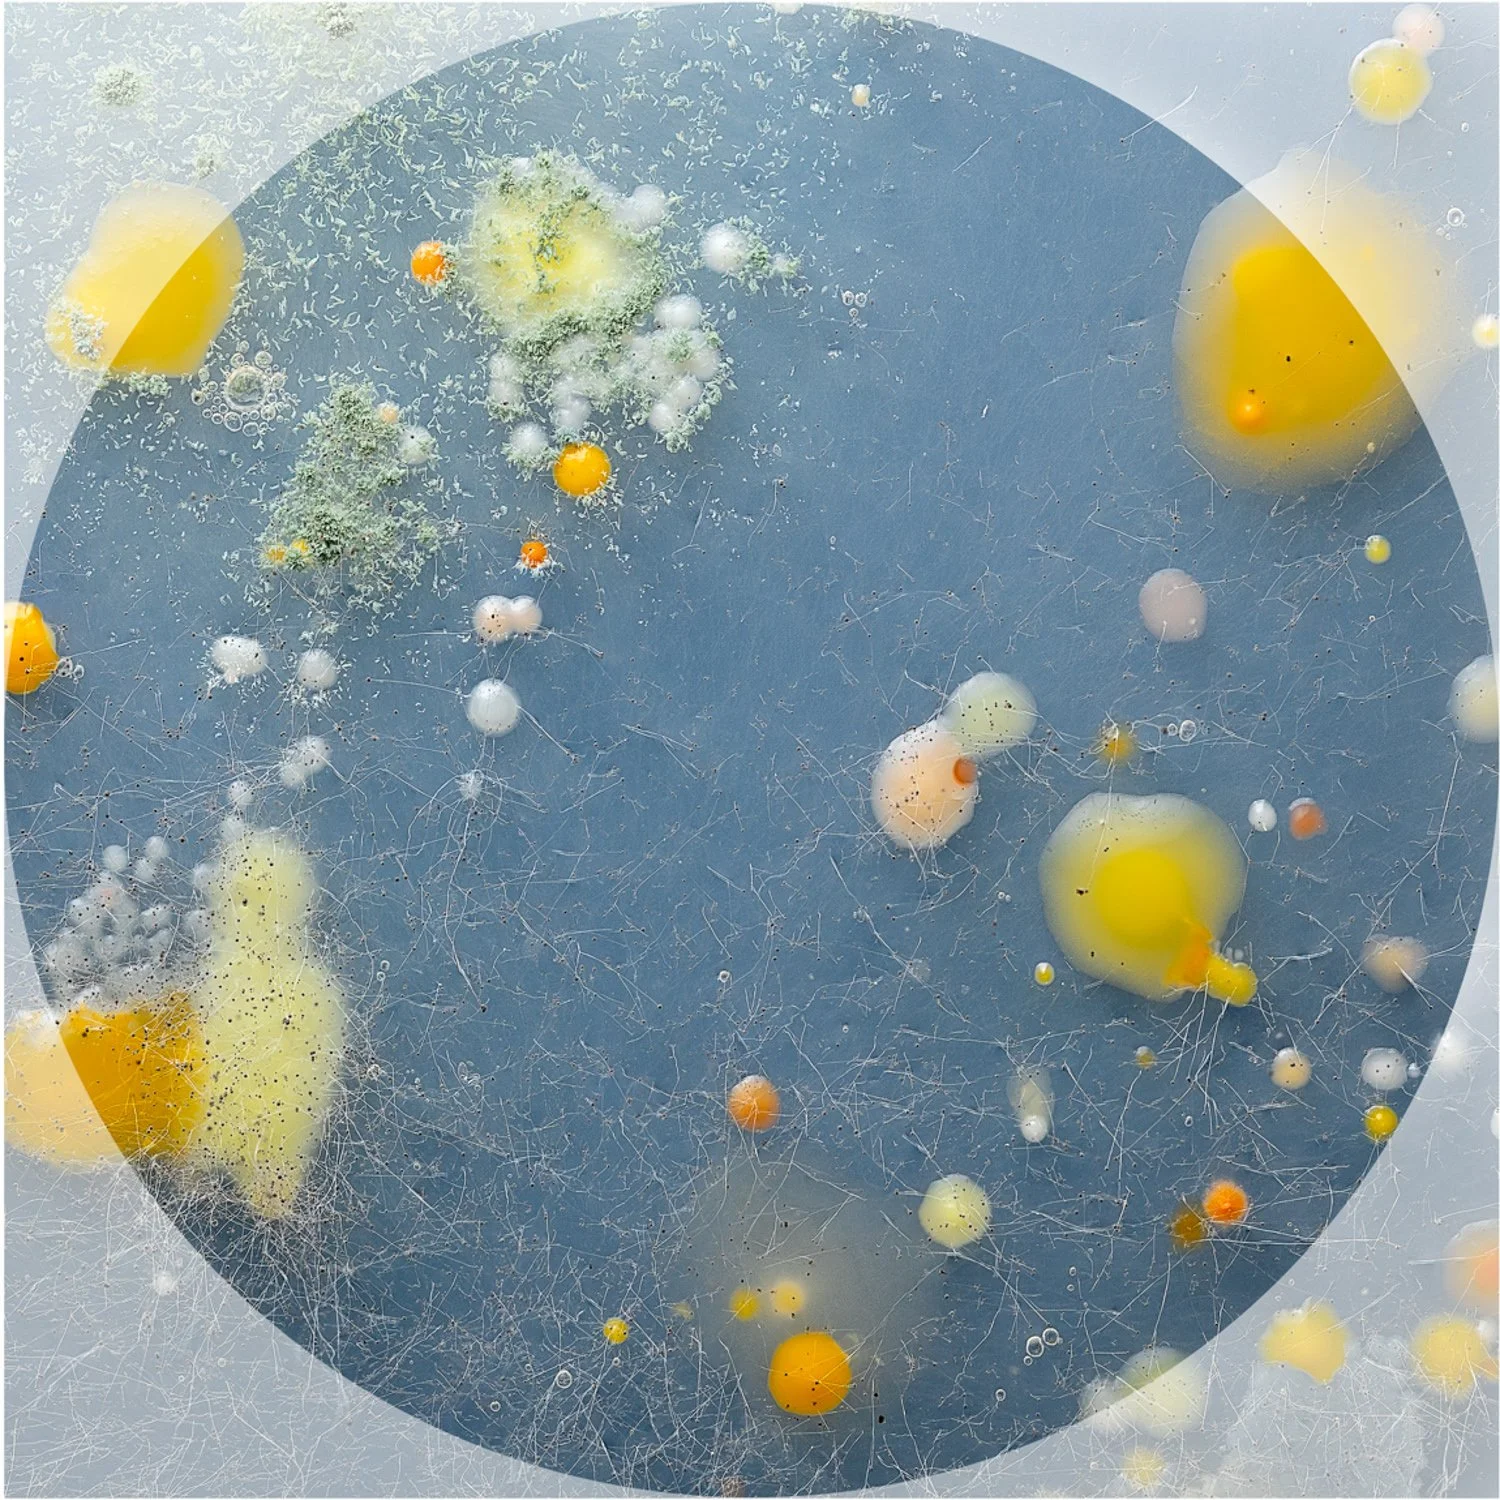
CW2.jpg
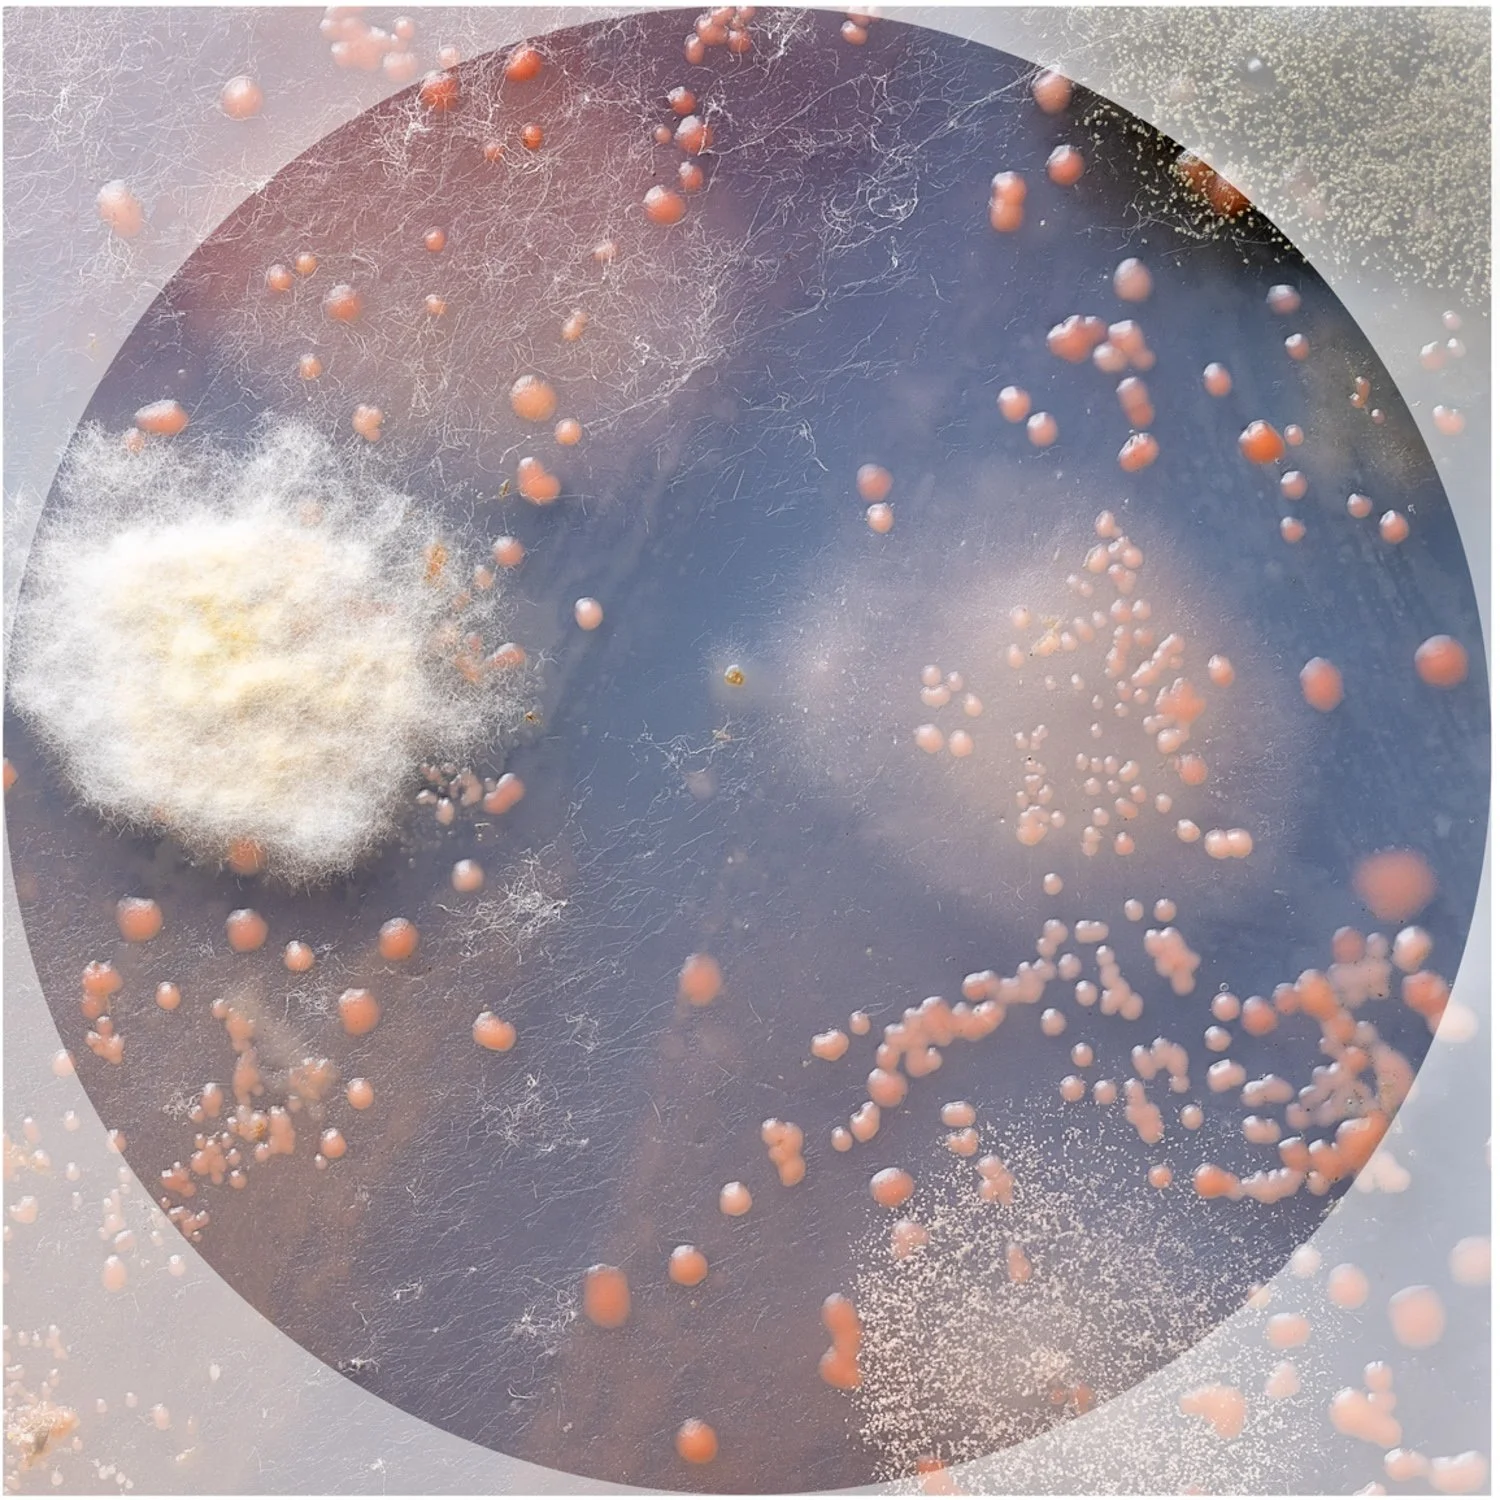
CD4.jpg
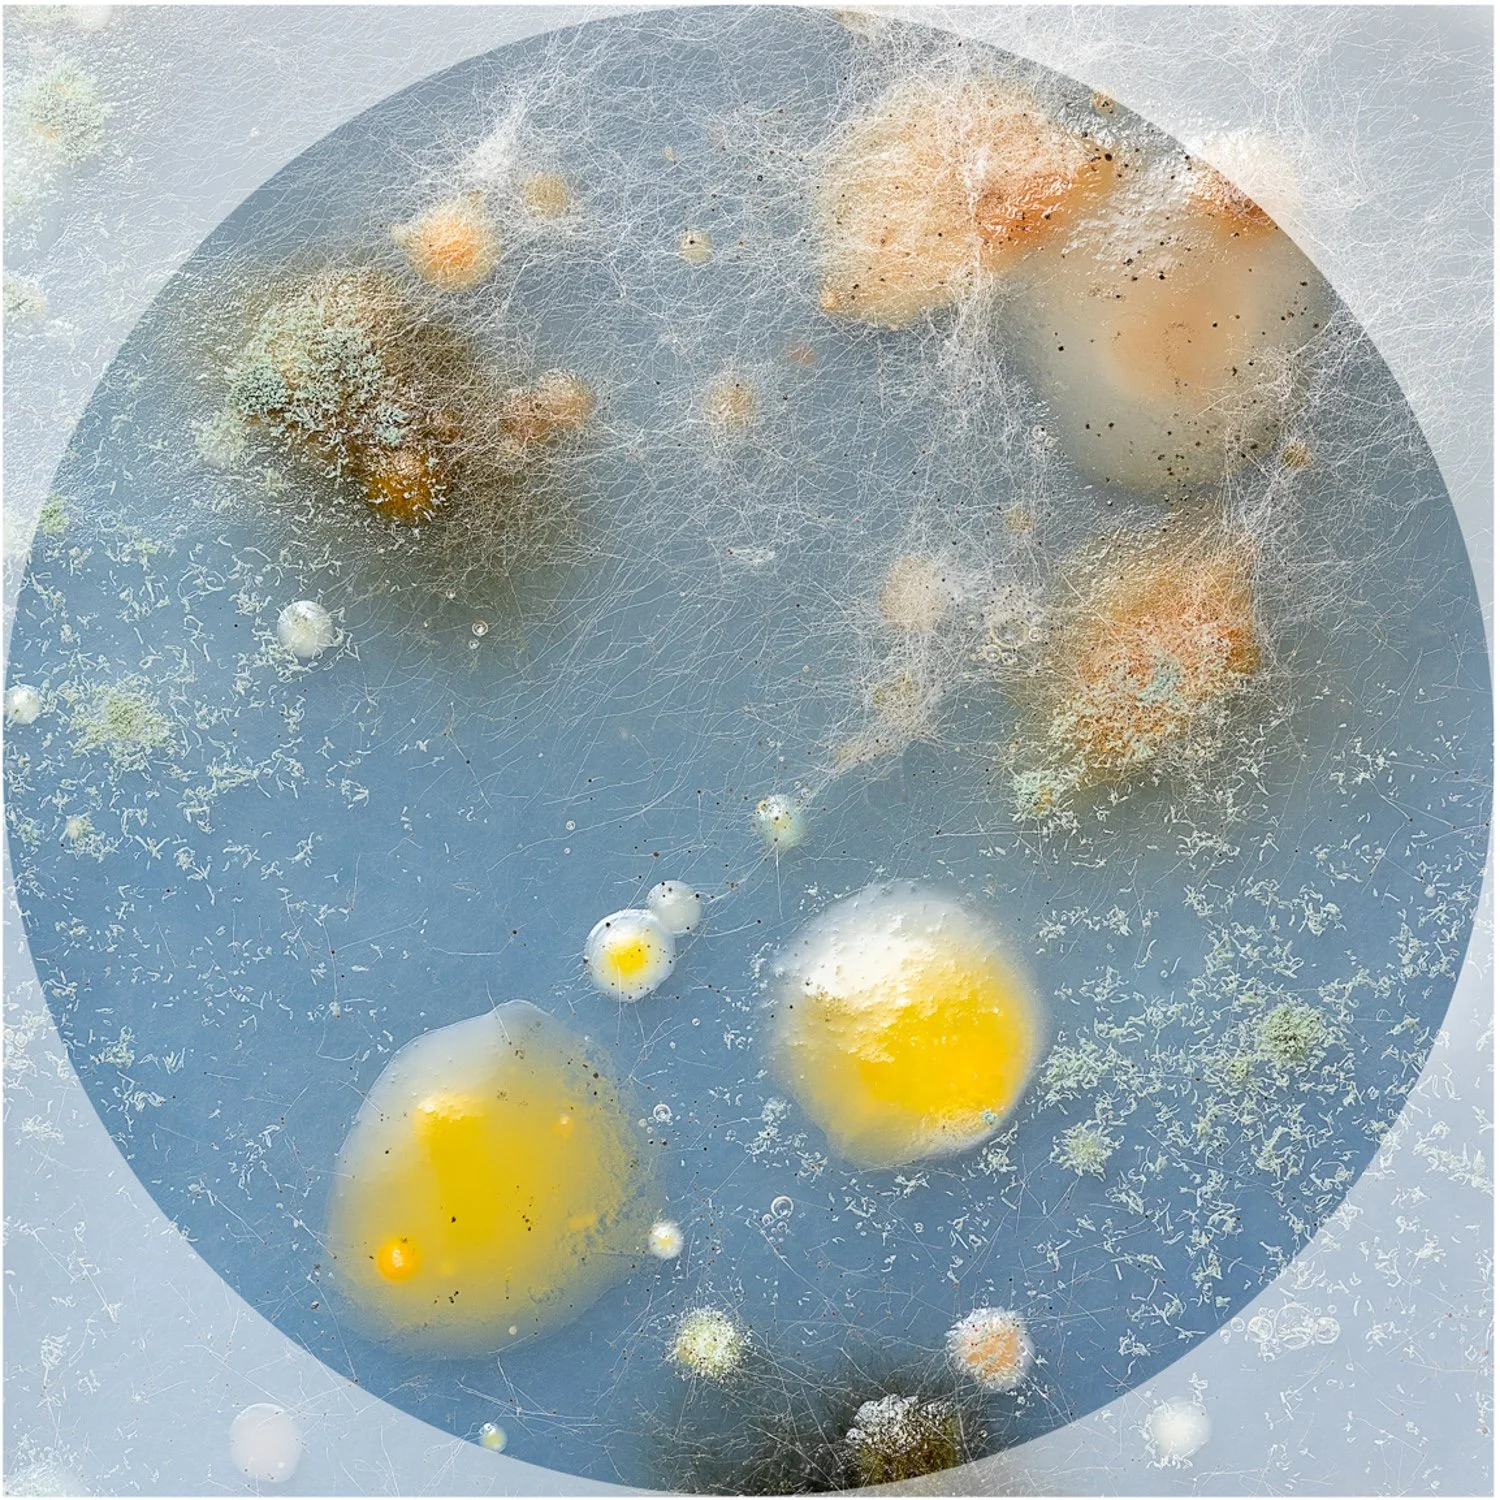
CW3.jpg
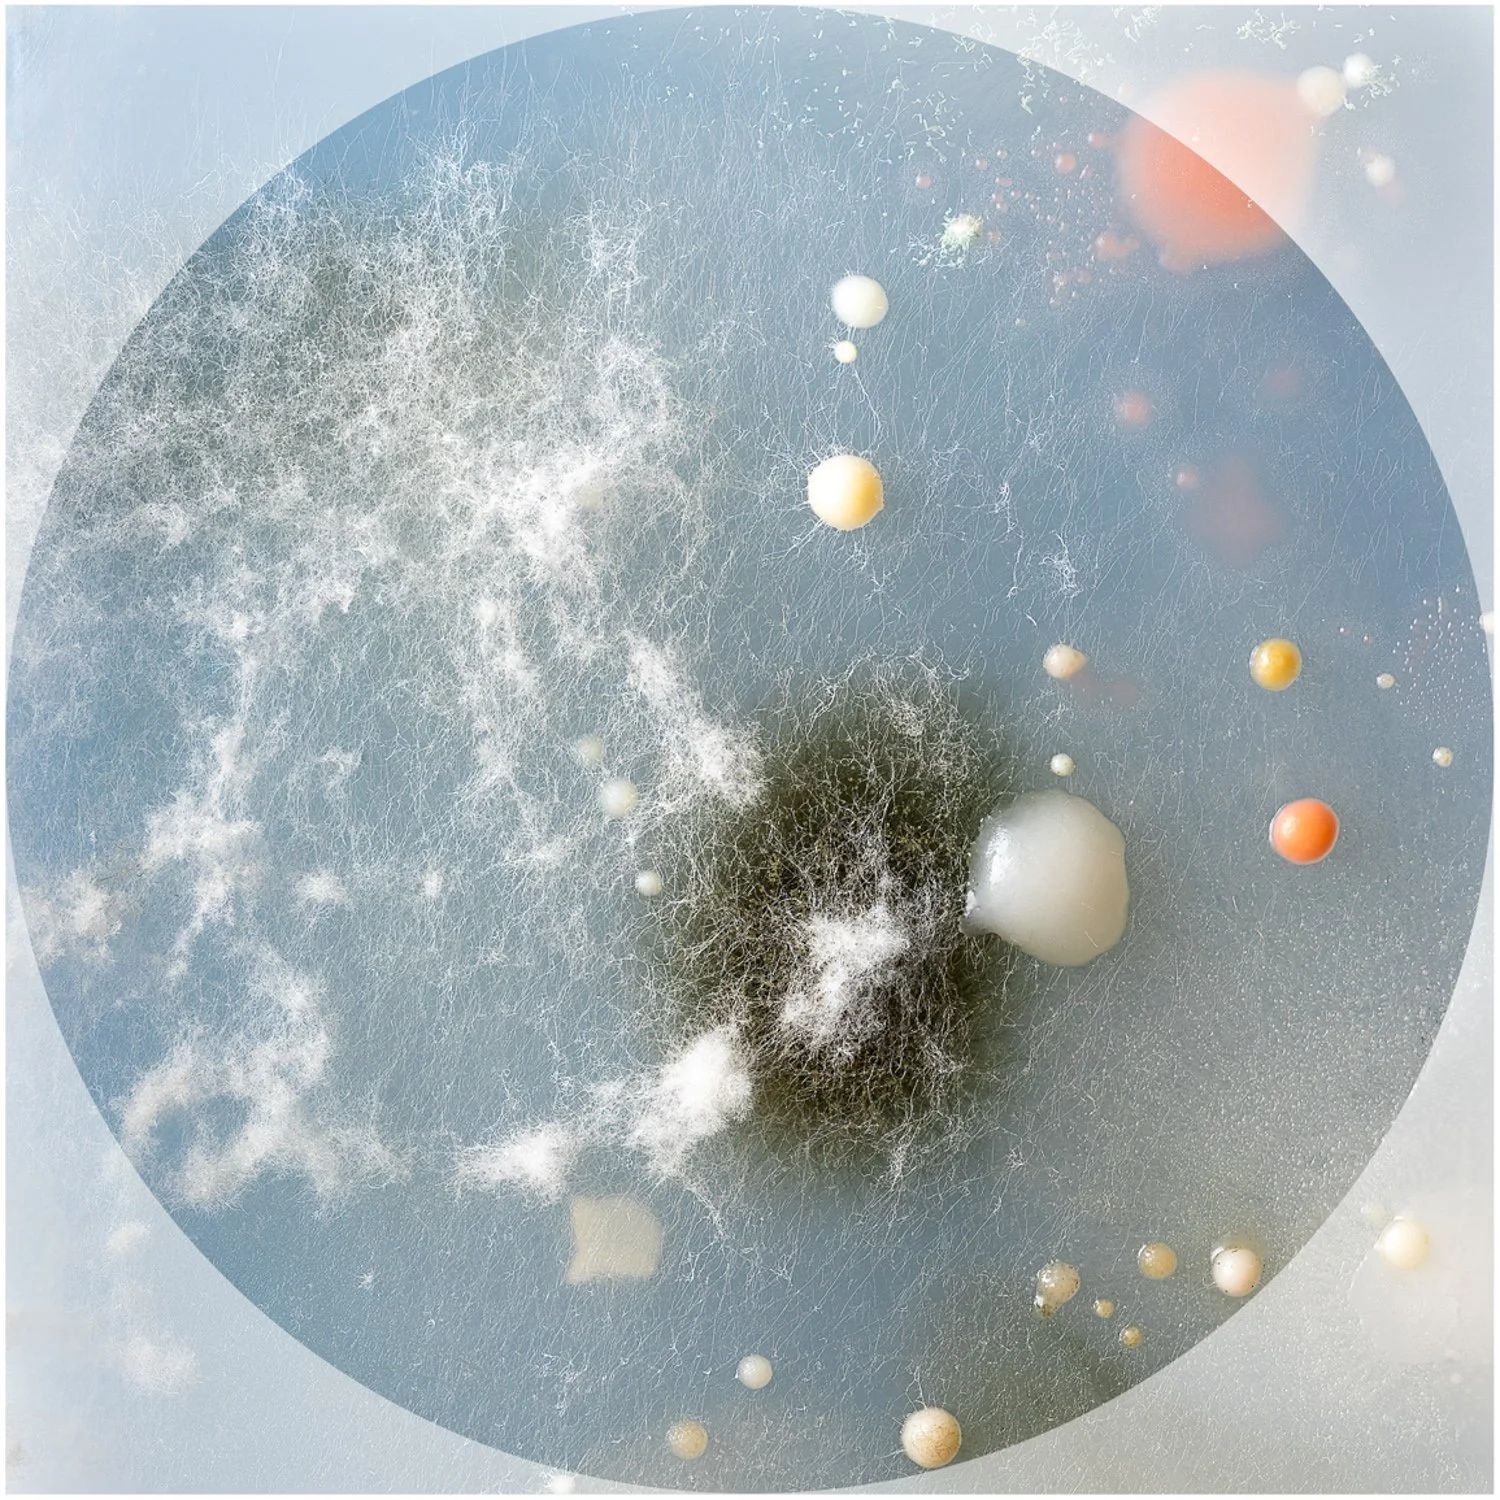
GP3.jpg
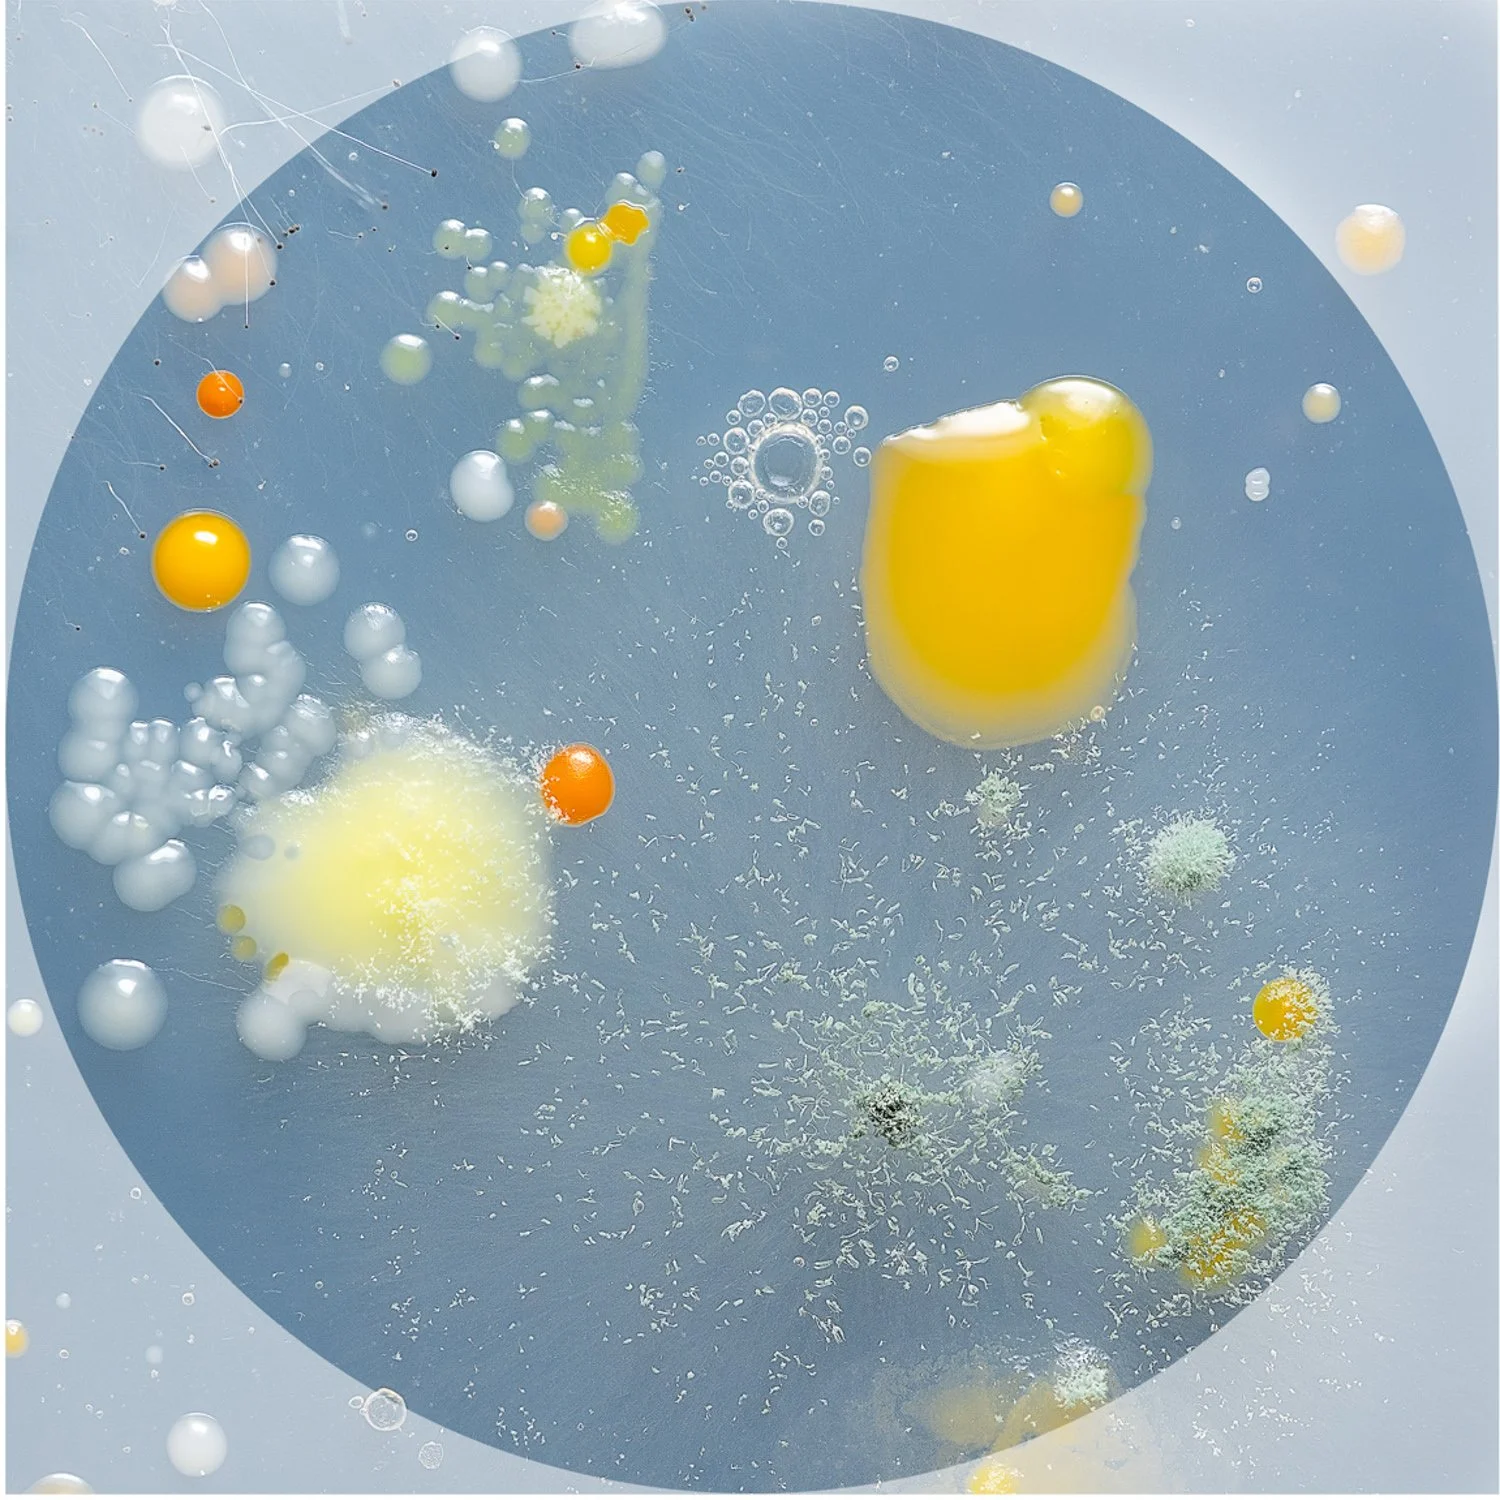
CW1.jpg
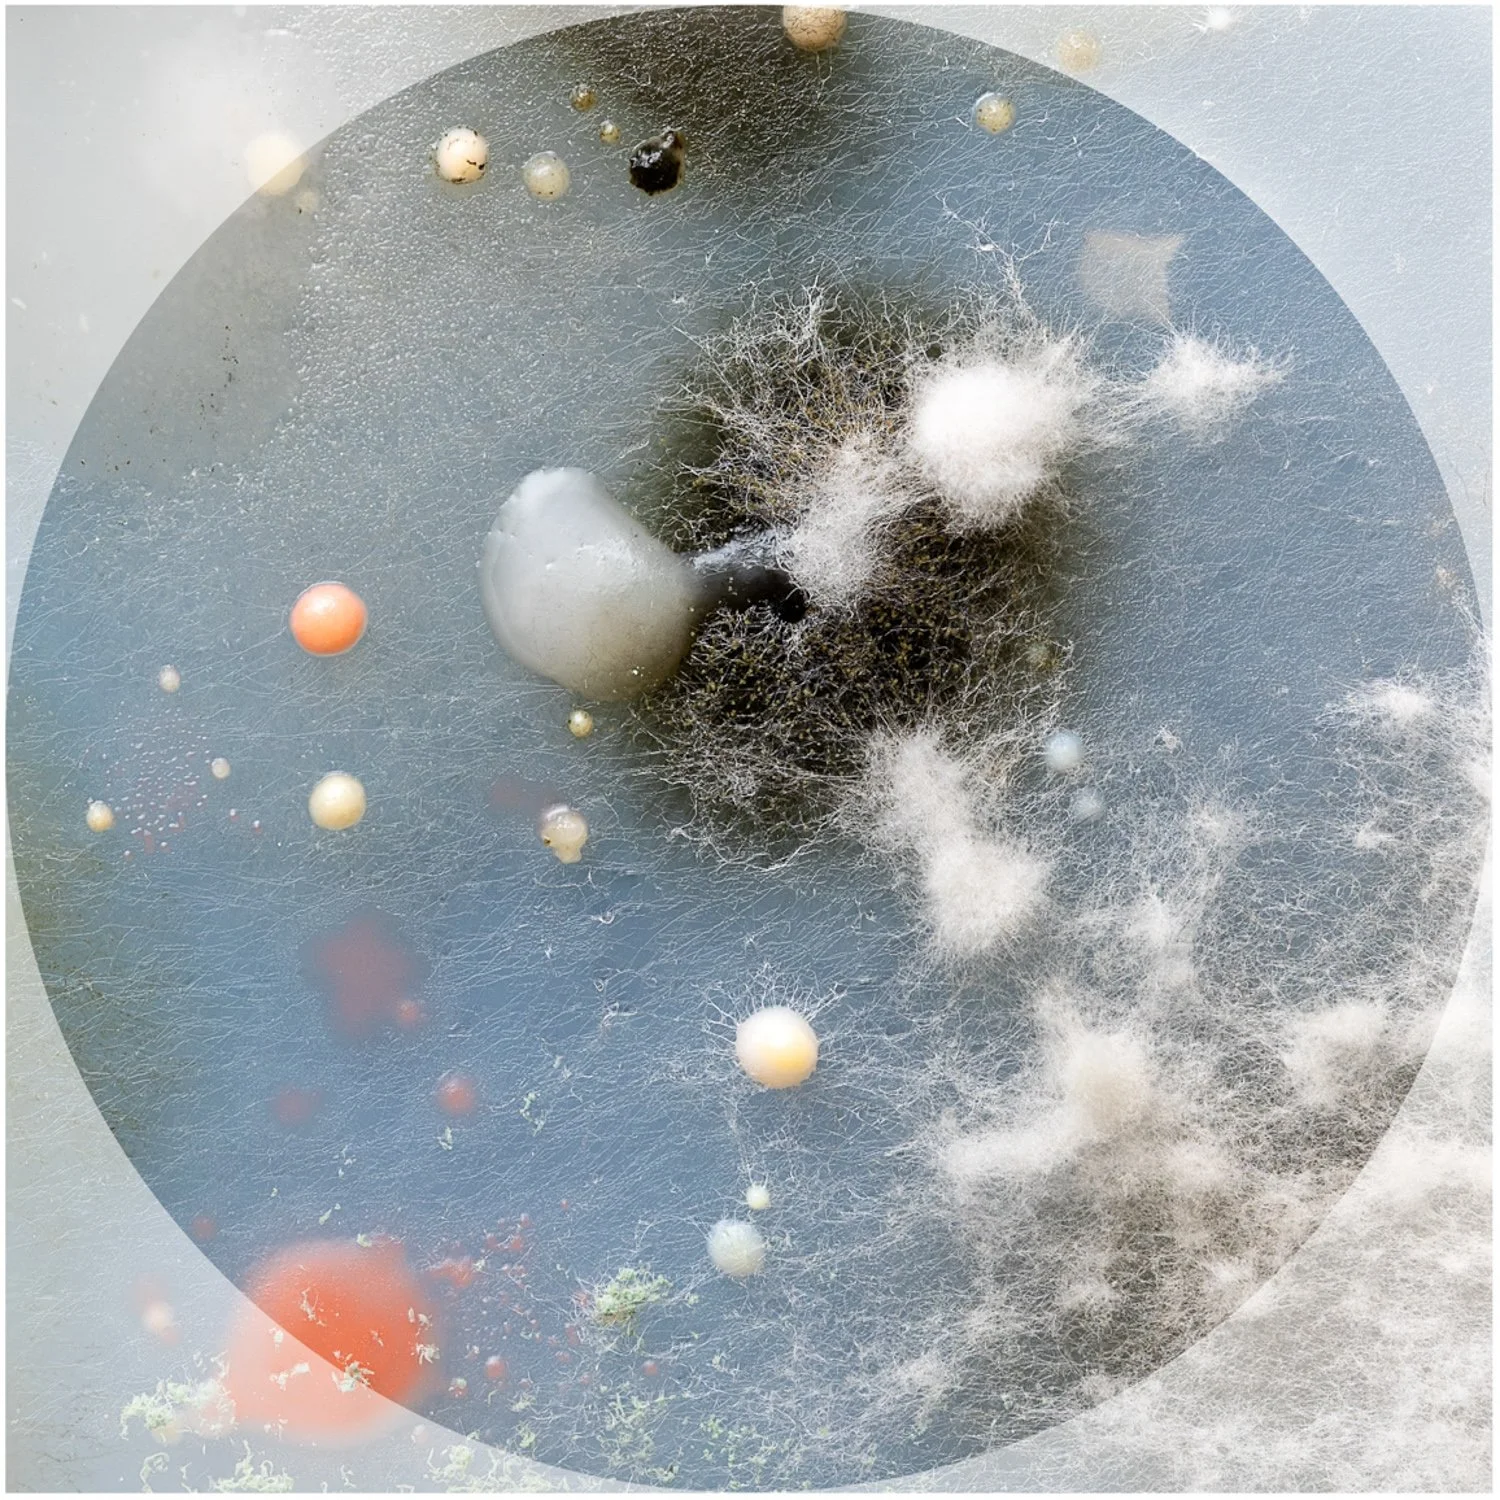
GP4.jpg

Dance
























Summit Road
An abstract journey









Beautiful Decay
















My Happy Place







Trees



Water Quality
Look at it this way…